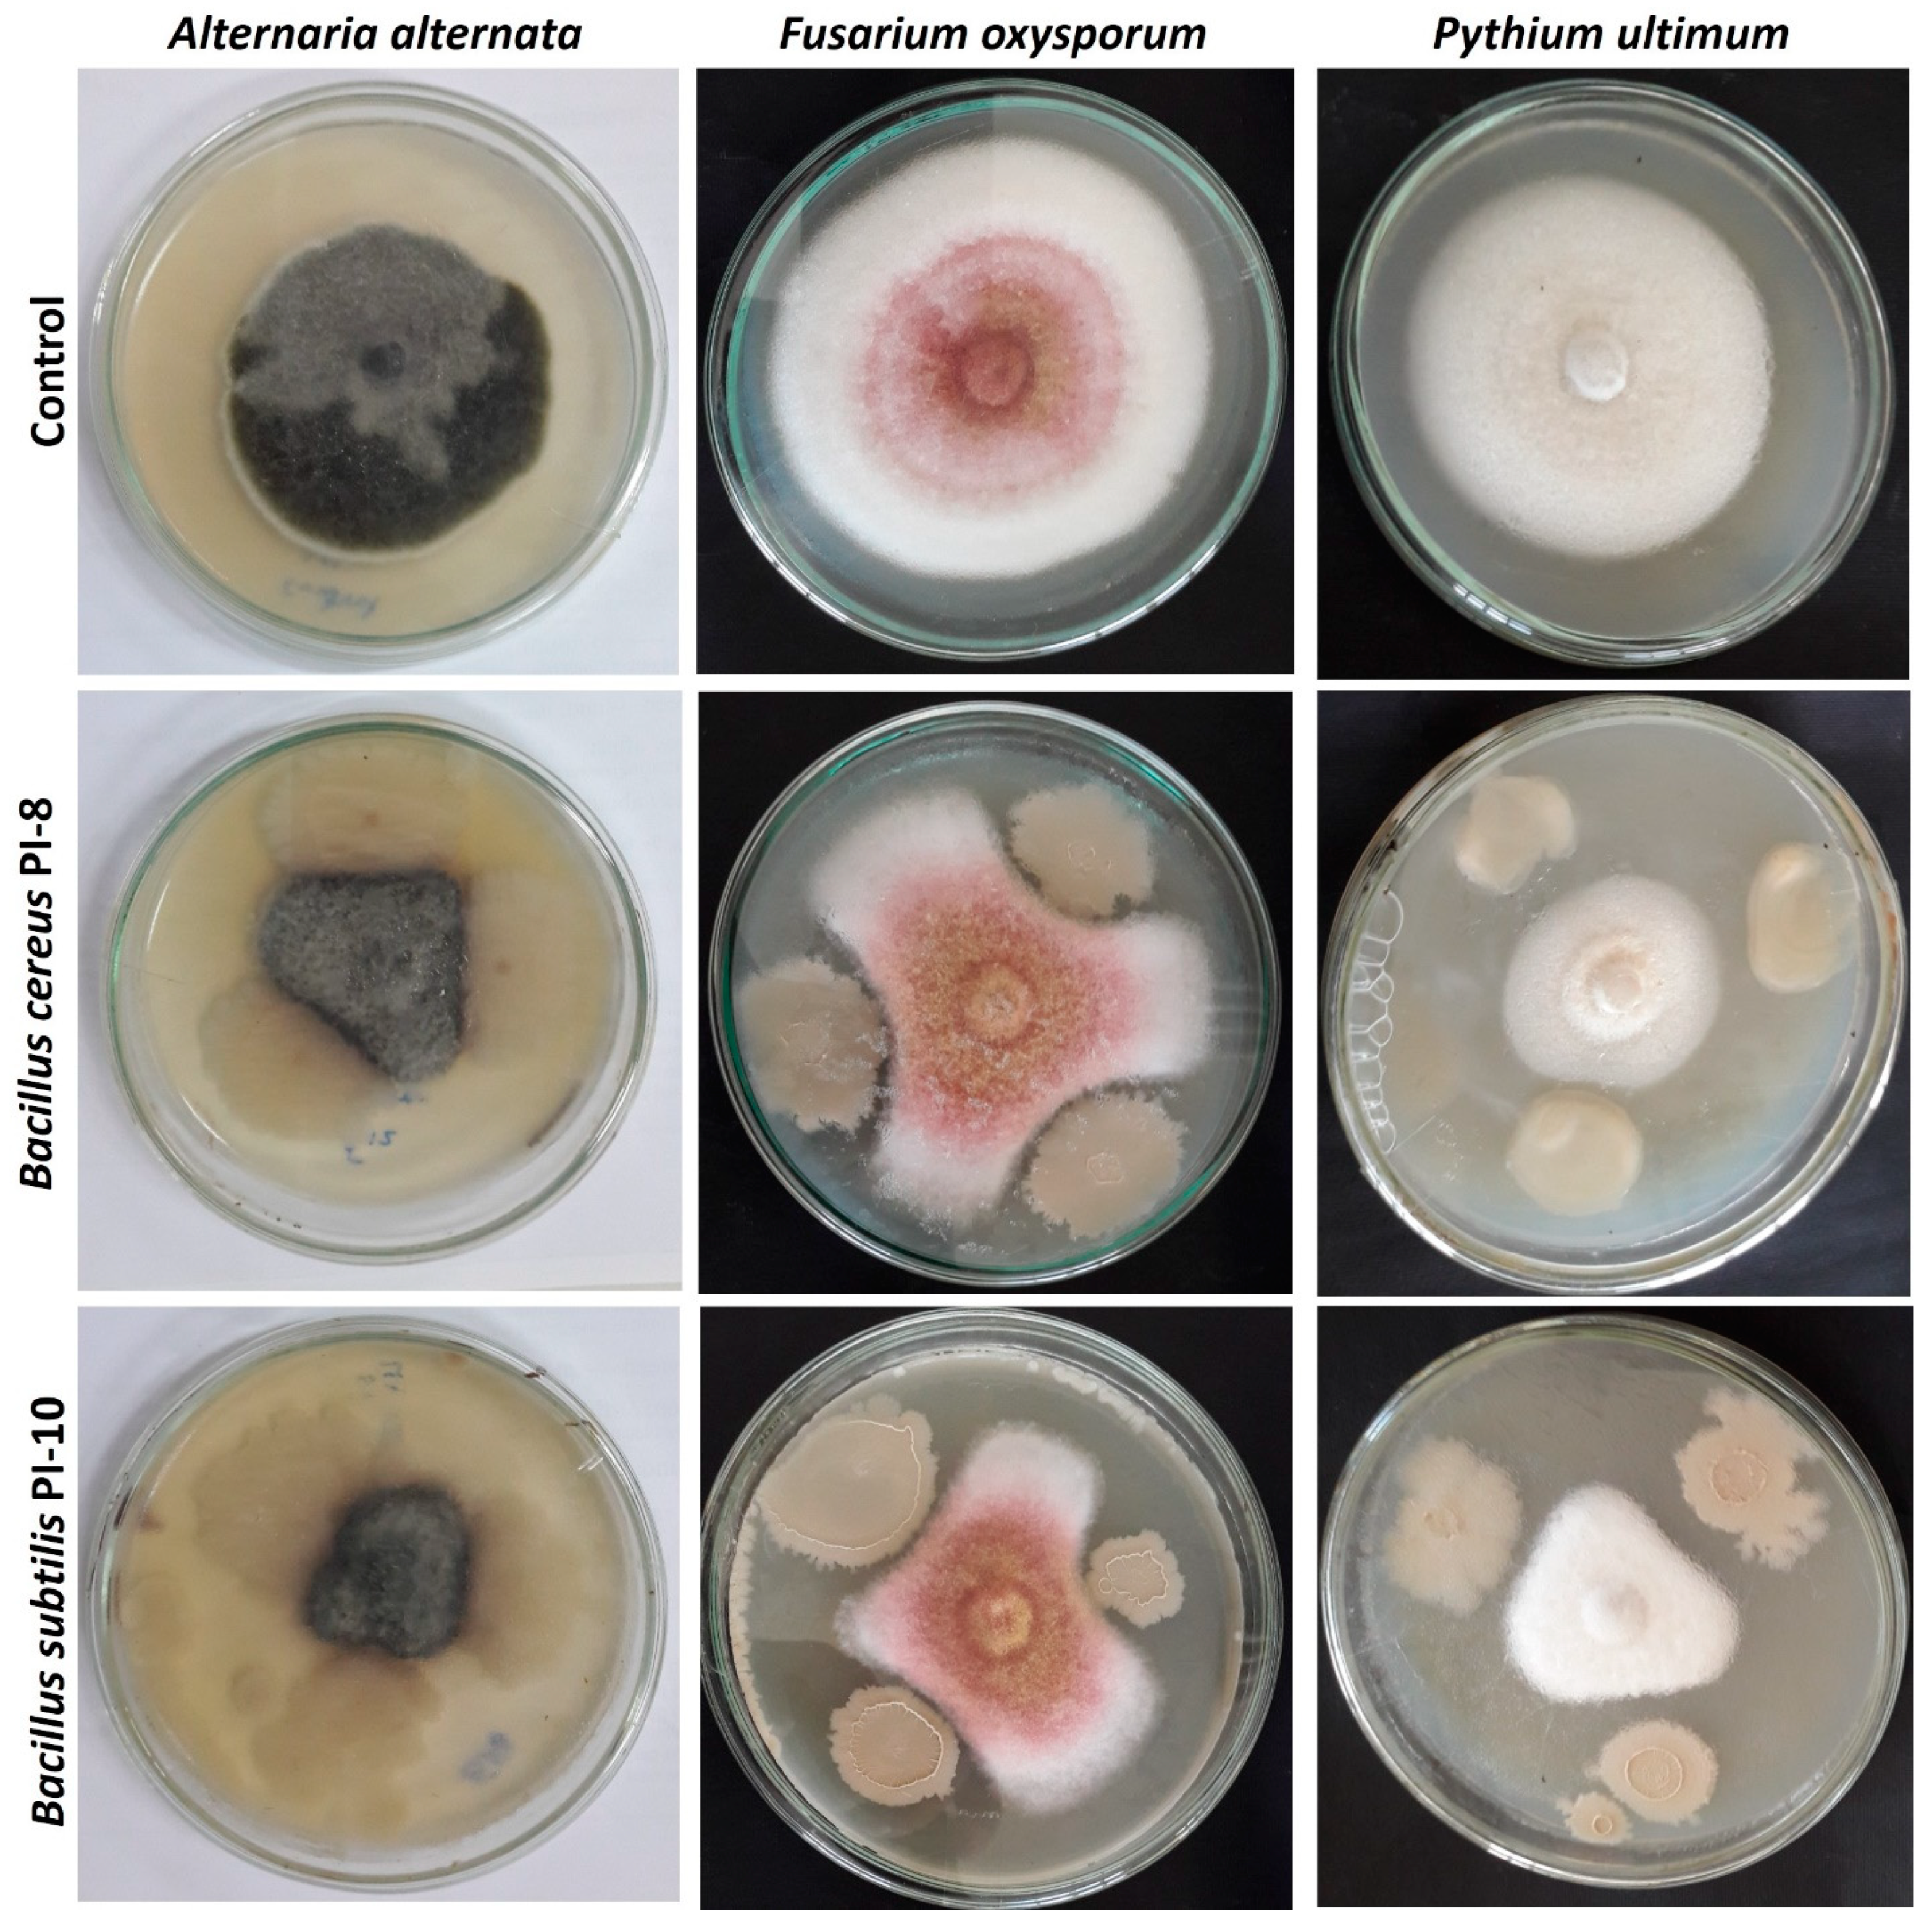
Plants 10 00076 g004

Plant Growth-Promoting Endophytic Bacterial Community Inhabiting the Leaves of Pulicaria incisa (Lam.) DC Inherent to Arid Regions
Abstract
1. Introduction
2. Results
2.1. Isolation and Identification of Bacterial Endophytes
2.2. Characterization of Endophytic Bacterial Strains
2.2.1. Salt Tolerance
2.2.2. Indole Acetic Acid (IAA) Synthesis
2.2.3. Extracellular Lytic Enzymatic Activities of Bacterial Endophytes
2.2.4. Ammonia Production and Solubilization of Phosphate
2.2.5. In Vitro Antagonistic Activity
2.3. Bio-Inoculations of Maize Root by the Most Potent Bacterial Strains
2.4. Greenhouse Experiment
3. Discussion
4. Materials and Methods
4.1. Material Used
4.2. Sample Collection
4.3. Isolation of Bacterial Endophytes
4.4. Identification of Endophytic Isolates
4.5. Characterization of Endophytic Bacteria
4.5.1. Salinity Tolerance
4.5.2. Indole Acetic Acid (IAA) Production by Bacterial Endophytes
4.5.3. Screening the Extracellular Enzymatic Activities of Bacterial Endophytes
4.5.4. Ammonia Production
4.5.5. Phosphate Solubilization Activity
4.5.6. In Vitro Antagonistic Bioassay
4.6. Effect of the Most Potent Endophytic Bacteria on Root Length of Zea mays Plant
Gnotobiotic Root Elongation Assay
4.7. Greenhouse Experiment
4.7.1. Experimental Design and Soil Analysis
4.7.2. Bacterial Inoculations
4.7.3. Plant Sample Analysis
4.8. Statistical Analysis
5. Conclusions
Author Contributions
Funding
Institutional Review Board Statement
Informed Consent Statement
Data Availability Statement
Acknowledgments
Conflicts of Interest
References
- Hegazy, A.K.; Emam, M.H.; Lovett-Doust, L.; Azab, E.; El-Khatib, A.A. Response of Duckweed to Lead Exposure: Phytomining, Bioindicators and Bioremediaton. Desalin Water Treat 2017, 70, 227–234. [Google Scholar] [CrossRef]
- Azab, E.; Elsalam, H.; Sharnouby, M. Performance of Catharanthus Roseus Plants in Response to Gamma Irradiation. J. Biol. Chem. Res. 2016, 33, 130–140. [Google Scholar]
- Habib, N.; Ali, Q.; Ali, S.; Javed, M.T.; Zulqurnain Haider, M.; Perveen, R.; Shahid, M.R.; Rizwan, M.; Abdel-Daim, M.M.; Elkelish, A.; et al. Use of Nitric Oxide and Hydrogen Peroxide for Better Yield of Wheat (Triticum aestivum L.) under Water Deficit Conditions: Growth, Osmoregulation, and Antioxidative Defense Mechanism. Plants 2020, 9, 285. [Google Scholar] [CrossRef] [PubMed]
- Soliman, M.; Alhaithloul, H.A.; Hakeem, K.R.; Alharbi, B.M.; El-Esawi, M.; Elkelish, A. Exogenous Nitric Oxide Mitigates Nickel-Induced Oxidative Damage in Eggplant by Upregulating Antioxidants, Osmolyte Metabolism, and Glyoxalase Systems. Plants 2019, 8, 562. [Google Scholar] [CrossRef]
- Elkelish, A.; Qari, S.H.; Mazrou, Y.S.A.; Abdelaal, K.A.A.; Hafez, Y.M.; Abu-Elsaoud, A.M.; Batiha, G.E.-S.; El-Esawi, M.A.; El Nahhas, N. Exogenous Ascorbic Acid Induced Chilling Tolerance in Tomato Plants Through Modulating Metabolism, Osmolytes, Antioxidants, and Transcriptional Regulation of Catalase and Heat Shock Proteins. Plants 2020, 9, 431. [Google Scholar] [CrossRef]
- Fouda, A.; Hassan, S.; Eid, A.M.; El-Din Ewais, E. The interaction between plants and bacterial endophytes under salinity stress. In Endophytes and Secondary Metabolites; Springer: Cham, Switzerland, 2019; pp. 1–18. [Google Scholar]
- Eid, A.M.; Salim, S.S.; Hassan, S.E.-D.; Ismail, M.A.; Fouda, A. Role of Endophytes in Plant Health and Abiotic Stress Management. In Microbiome in Plant Health and Disease: Challenges and Opportunities; Kumar, V., Prasad, R., Kumar, M., Choudhary, D.K., Eds.; Springer: Singapore, 2019; pp. 119–144. [Google Scholar]
- ALKahtani, M.D.; Fouda, A.; Attia, K.A.; Al-Otaibi, F.; Eid, A.M.; Ewais, E.E.-D.; Hijri, M.; St-Arnaud, M.; Hassan, S.E.-D.; Khan, N. Isolation and Characterization of Plant Growth Promoting Endophytic Bacteria from Desert Plants and Their Application as Bioinoculants for Sustainable Agriculture. Agronomy 2020, 10, 1325. [Google Scholar] [CrossRef]
- Ahemad, M.; Kibret, M. Mechanisms and applications of plant growth promoting rhizobacteria: Current perspective. J. King Saud Univ. Sci. 2014, 26, 1–20. [Google Scholar] [CrossRef]
- Hassan, S.E.D.; Fouda, A.; Radwan, A.A.; Salem, S.S.; Barghoth, M.G.; Awad, M.A.; Abdo, A.M.; El-Gamal, M.S. Endophytic actinomycetes Streptomyces spp mediated biosynthesis of copper oxide nanoparticles as a promising tool for biotechnological applications. J. Biol. Inorg. Chem. 2019, 24, 377–393. [Google Scholar] [CrossRef]
- Fouda, A.; Hassan, S.E.D.; Abdo, A.M.; El-Gamal, M.S. Antimicrobial, Antioxidant and Larvicidal Activities of Spherical Silver Nanoparticles Synthesized by Endophytic Streptomyces spp. Biol. Trace Elem. Res. 2020, 195, 707–724. [Google Scholar] [CrossRef]
- Eid, A.M.; Fouda, A.; Niedbała, G.; Hassan, S.E.-D.; Salem, S.S.; Abdo, A.M.; Hetta, H.; Shaheen, T.I. Endophytic Streptomyces laurentii Mediated Green Synthesis of Ag-NPs with Antibacterial and Anticancer Properties for Developing Functional Textile Fabric Properties. Antibiotics 2020, 9, 641. [Google Scholar] [CrossRef]
- Soliman, M.; Elkelish, A.; Souad, T.; Alhaithloul, H.; Farooq, M. Brassinosteroid Seed Priming with Nitrogen Supplementation Improves Salt Tolerance in Soybean. Physiol Mol. Biol. Plants 2020, 26, 501–511. [Google Scholar] [CrossRef] [PubMed]
- Murphy, B.R.; Doohan, F.M.; Hodkinson, T.R. Yield increase induced by the fungal root endophyte Piriformospora indica in barley grown at low temperature is nutrient limited. Symbiosis 2014, 62, 29–39. [Google Scholar] [CrossRef]
- Khan, A.L.; Hamayun, M.; Kang, S.-M.; Kim, Y.-H.; Jung, H.-Y.; Lee, J.-H.; Lee, I.-J. Endophytic fungal association via gibberellins and indole acetic acid can improve plant growth under abiotic stress: An example of Paecilomyces formosus LHL10. BMC Microbiol. 2012, 12, 3. [Google Scholar] [CrossRef] [PubMed]
- Matsuoka, H.; Akiyama, M.; Kobayashi, K.; Yamaji, K. Fe and P Solubilization Under Limiting Conditions by Bacteria Isolated from Carex kobomugi Roots at the Hasaki Coast. Curr. Microbiol. 2013, 66, 314–321. [Google Scholar] [CrossRef]
- Shi, Y.; Lou, K.; Li, C. Growth promotion effects of the endophyte Acinetobacter johnsonii strain 3-1 on sugar beet. Symbiosis 2011, 54, 159–166. [Google Scholar] [CrossRef]
- Malhadas, C.; Malheiro, R.; Pereira, J.A.; de Pinho, P.G.; Baptista, P. Antimicrobial activity of endophytic fungi from olive tree leaves. World J. Microbiol. Biotechnol. 2017, 33, 46. [Google Scholar] [CrossRef]
- Hassan, S.E.-D. Plant growth-promoting activities for bacterial and fungal endophytes isolated from medicinal plant of Teucrium polium L. J. Adv. Res. 2017, 8, 687–695. [Google Scholar] [CrossRef]
- El-Shahaby, O.; El-Zayat, M.; Rabei, R.; Aldesuquy, H.S. Phytochemical constituents, antioxidant activity and antimicrobial potential of Pulicaria incisa (lam.) DC as a folk medicinal plant. Prog. Chem. Biochem. Res. 2019, 2, 222–227. [Google Scholar]
- Saleh, N. Global phytochemistry: The Egyptian experience. Phytochemistry 2003, 63, 239. [Google Scholar] [CrossRef]
- Stavri, M.; Mathew, K.T.; Gordon, A.; Shnyder, S.D.; Falconer, R.A.; Gibbons, S. Guaianolide sesquiterpenes from Pulicaria crispa (Forssk.) Oliv. Phytochemistry 2008, 69, 1915–1918. [Google Scholar] [CrossRef]
- Shahat, E.A.; Bakr, R.O.; Eldahshan, O.A.; Ayoub, N.A. Chemical Composition and Biological Activities of the Essential Oil from Leaves and Flowers of Pulicaria incisa sub. candolleana (Family Asteraceae). Chem. Biodivers. 2017, 14, e1600156. [Google Scholar] [CrossRef] [PubMed]
- Costa, L.E.d.O.; Queiroz, M.V.d.; Borges, A.C.; Moraes, C.A.d.; Araújo, E.F.d. Isolation and characterization of endophytic bacteria isolated from the leaves of the common bean (Phaseolus vulgaris). Braz. J. Microbiol. 2012, 43, 1562–1575. [Google Scholar] [CrossRef]
- Vendan, R.T.; Yu, Y.J.; Lee, S.H.; Rhee, Y.H. Diversity of endophytic bacteria in ginseng and their potential for plant growth promotion. J. Microbiol. 2010, 48, 559–565. [Google Scholar] [CrossRef] [PubMed]
- Zhao, L.; Xu, Y.; Lai, X.-H.; Shan, C.; Deng, Z.; Ji, Y. Screening and characterization of endophytic Bacillus and Paenibacillus strains from medicinal plant Lonicera japonica for use as potential plant growth promoters. Braz. J. Microbiol. 2015, 46, 977–989. [Google Scholar] [CrossRef]
- Zhang, Y.Z.; Chen, W.F.; Li, M.; Sui, X.H.; Liu, H.-C.; Zhang, X.X.; Chen, W.X. Bacillus endoradicis sp. nov. an endophytic bacterium isolated from soybean root. Int. J. Syst. Evol. Microbiol. 2012, 62, 359–363. [Google Scholar] [CrossRef]
- Hanna, A.L.; Youssef, H.H.; Amer, W.M.; Monib, M.; Fayez, M.; Hegazi, N.A. Diversity of bacteria nesting the plant cover of north Sinai deserts, Egypt. J. Adv. Res. 2013, 4, 13–26. [Google Scholar] [CrossRef]
- Romero, F.M.; Marina, M.; Pieckenstain, F.L. The communities of tomato (Solanum lycopersicum L.) leaf endophytic bacteria, analyzed by 16S-ribosomal RNA gene pyrosequencing. FEMS Microbiol. Lett. 2014, 351, 187–194. [Google Scholar] [CrossRef]
- Shi, Y.; Yang, H.; Zhang, T.; Sun, J.; Lou, K. Illumina-based analysis of endophytic bacterial diversity and space-time dynamics in sugar beet on the north slope of Tianshan mountain. Appl. Microbiol. Biotechnol. 2014, 98, 6375–6385. [Google Scholar] [CrossRef]
- Venieraki, A.; Dimou, M.; Pergalis, P.; Kefalogianni, I.; Chatzipavlidis, I.; Katinakis, P. The Genetic Diversity of Culturable Nitrogen-Fixing Bacteria in the Rhizosphere of Wheat. Microb. Ecol. 2011, 61, 277–285. [Google Scholar] [CrossRef]
- Wulff, E.; Van Vuurde, J.; Hockenhull, J. The ability of the biological control agent Bacillus subtilis, strain BB, to colonise vegetable brassicas endophytically following seed inoculation. Plant Soil 2003, 255, 463–474. [Google Scholar] [CrossRef]
- Miller, K.I.; Qing, C.; Sze, D.M.-Y.; Roufogalis, B.D.; Neilan, B.A. Culturable endophytes of medicinal plants and the genetic basis for their bioactivity. Microb. Ecol. 2012, 64, 431–449. [Google Scholar] [CrossRef]
- de Almeida Lopes, K.B.; Carpentieri-Pipolo, V.; Oro, T.H.; Stefani Pagliosa, E.; Degrassi, G. Culturable endophytic bacterial communities associated with field-grown soybean. J. Appl. Microbiol. 2016, 120, 740–755. [Google Scholar] [CrossRef] [PubMed]
- Shan, C.; Mei, Z.; Duan, J.; Chen, H.; Feng, H.; Cai, W. OsGA2ox5, a gibberellin metabolism enzyme, is involved in plant growth, the root gravity response and salt stress. PLoS ONE 2014, 9, e87110. [Google Scholar] [CrossRef]
- Mishra, I.G.; Sharma, A. Exogenously supplied osmoprotectants confer enhanced salinity tolerance in rhizobacteria. J. Ecobiotechnol. 2012, 4, 11–13. [Google Scholar]
- Upadhyay, S.; Singh, J.; Singh, D. Exopolysaccharide-producing plant growth-promoting rhizobacteria under salinity condition. Pedosphere 2011, 21, 214–222. [Google Scholar] [CrossRef]
- Yaish, M.W.; Antony, I.; Glick, B.R. Isolation and characterization of endophytic plant growth-promoting bacteria from date palm tree (Phoenix dactylifera L.) and their potential role in salinity tolerance. Antonie Van Leeuwenhoek 2015, 107, 1519–1532. [Google Scholar] [CrossRef] [PubMed]
- Lin, L.; Xu, X. Indole-3-Acetic Acid Production by Endophytic Streptomyces sp. En-1 Isolated from Medicinal Plants. Curr. Microbiol. 2013, 67, 209–217. [Google Scholar] [CrossRef] [PubMed]
- Sarwar, M.; Frankenberger, W.T. Influence of L-tryptophan and auxins applied to the rhizosphere on the vegetative growth of Zea mays L. Plant Soil 1994, 160, 97–104. [Google Scholar] [CrossRef]
- Overvoorde, P.; Fukaki, H.; Beeckman, T. Auxin control of root development. Cold Spring Harb. Perspect. Biol. 2010, 2, a001537. [Google Scholar] [CrossRef] [PubMed]
- Khan, A.L.; Waqas, M.; Kang, S.-M.; Al-Harrasi, A.; Hussain, J.; Al-Rawahi, A.; Al-Khiziri, S.; Ullah, I.; Ali, L.; Jung, H.-Y. Bacterial endophyte Sphingomonas sp. LK11 produces gibberellins and IAA and promotes tomato plant growth. J. Microbiol. 2014, 52, 689–695. [Google Scholar] [CrossRef]
- Bianco, C.; Imperlini, E.; Defez, R. Legumes like more IAA. Plant Signal. Behav. 2009, 4, 763–765. [Google Scholar] [CrossRef] [PubMed]
- Dobbelaere, S.; Vanderleyden, J.; Okon, Y. Plant Growth-Promoting Effects of Diazotrophs in the Rhizosphere. Crit. Rev. Plant Sci. 2003, 22, 107–149. [Google Scholar] [CrossRef]
- Dawwam, G.E.; Elbeltagy, A.; Emara, H.M.; Abbas, I.H.; Hassan, M.M. Beneficial effect of plant growth promoting bacteria isolated from the roots of potato plant. Ann. Agric. Sci. 2013, 58, 195–201. [Google Scholar] [CrossRef]
- Fouda, A.H.; Hassan, S.E.-D.; Eid, A.M.; Ewais, E.E.-D. Biotechnological applications of fungal endophytes associated with medicinal plant Asclepias sinaica (Bioss.). Ann. Agric. Sci. 2015, 60, 95–104. [Google Scholar] [CrossRef]
- Castro, R.A.; Quecine, M.C.; Lacava, P.T.; Batista, B.D.; Luvizotto, D.M.; Marcon, J.; Ferreira, A.; Melo, I.S.; Azevedo, J.L. Isolation and enzyme bioprospection of endophytic bacteria associated with plants of Brazilian mangrove ecosystem. SpringerPlus 2014, 3, 382. [Google Scholar] [CrossRef]
- Glick, B.R. Plant growth-promoting bacteria: Mechanisms and applications. Scientifica 2012, 2012. [Google Scholar] [CrossRef]
- Kumar, A.; Kumar, A.; Devi, S.; Patil, S.; Payal, C.; Negi, S. Isolation, screening and characterization of bacteria from rhizospheric soils for different plant growth promotion (PGP) activities: An in vitro study. Recent Res. Sci. Technol. 2012, 4, 1–5. [Google Scholar]
- Hallmann, J.; Quadt-Hallmann, A.; Mahaffee, W.; Kloepper, J. Bacterial endophytes in agricultural crops. Can. J. Microbiol. 1997, 43, 895–914. [Google Scholar] [CrossRef]
- Zaferanloo, B.; Virkar, A.; Mahon, P.J.; Palombo, E.A. Endophytes from an Australian native plant are a promising source of industrially useful enzymes. World J. Microbiol. Biotechnol. 2013, 29, 335–345. [Google Scholar] [CrossRef]
- Afzal, I.; Iqrar, I.; Shinwari, Z.K.; Yasmin, A. Plant growth-promoting potential of endophytic bacteria isolated from roots of wild Dodonaea viscosa L. Plant Growth Regul. 2017, 81, 399–408. [Google Scholar] [CrossRef]
- Passari, A.K.; Mishra, V.K.; Leo, V.V.; Gupta, V.K.; Singh, B.P. Phytohormone production endowed with antagonistic potential and plant growth promoting abilities of culturable endophytic bacteria isolated from Clerodendrum colebrookianum Walp. Microbiol. Res. 2016, 193, 57–73. [Google Scholar] [CrossRef] [PubMed]
- Lovell, R.; Harvey, D. A preliminary study of ammonia production by Corynebacterium renale and some other pathogenic bacteria. Microbiology 1950, 4, 493–500. [Google Scholar] [CrossRef] [PubMed]
- Rodrigues, A.A.; Forzani, M.V.; Soares, R.d.S.; Sibov, S.T.; Vieira, J.D.G. Isolation and selection of plant growth-promoting bacteria associated with sugarcane. Pesqui. Agropecuária Trop. 2016, 46, 149–158. [Google Scholar] [CrossRef]
- Emami, S.; Alikhani, H.A.; Pourbabaee, A.A.; Etesami, H.; Motasharezadeh, B.; Sarmadian, F. Consortium of endophyte and rhizosphere phosphate solubilizing bacteria improves phosphorous use efficiency in wheat cultivars in phosphorus deficient soils. Rhizosphere 2020, 14, 100196. [Google Scholar] [CrossRef]
- Walia, A.; Guleria, S.; Chauhan, A.; Mehta, P. Endophytic Bacteria: Role in Phosphate Solubilization. In Endophytes: Crop Productivity and Protection: Volume 2; Maheshwari, D.K., Annapurna, K., Eds.; Springer International Publishing: Cham, Switzerland, 2017; pp. 61–93. [Google Scholar]
- Chebotar, V.; Malfanova, N.; Shcherbakov, A.; Ahtemova, G.; Borisov, A.Y.; Lugtenberg, B.; Tikhonovich, I. Endophytic bacteria in microbial preparations that improve plant development. Appl. Biochem. Microbiol. 2015, 51, 271–277. [Google Scholar] [CrossRef]
- Fadiji, A.E.; Babalola, O.O. Elucidating Mechanisms of Endophytes Used in Plant Protection and Other Bioactivities With Multifunctional Prospects. Front. Bioeng. Biotechnol. 2020, 8, 467. [Google Scholar] [CrossRef]
- Andreolli, M.; Lampis, S.; Zapparoli, G.; Angelini, E.; Vallini, G. Diversity of bacterial endophytes in 3 and 15 year-old grapevines of Vitis vinifera cv. Corvina and their potential for plant growth promotion and phytopathogen control. Microbiol. Res. 2016, 183, 42–52. [Google Scholar] [CrossRef]
- Douriet-Gámez, N.R.; Maldonado-Mendoza, I.E.; Ibarra-Laclette, E.; Blom, J.; Calderón-Vázquez, C.L. Genomic Analysis of Bacillus sp. Strain B25, a Biocontrol Agent of Maize Pathogen Fusarium verticillioides. Curr. Microbiol. 2018, 75, 247–255. [Google Scholar] [CrossRef]
- Silva, C.F.; Vitorino, L.C.; Mendonça, M.A.C.; Araújo, W.L.; Dourado, M.N.; Albuquerque, L.C.; Soares, M.A.; Souchie, E.L. Screening of plant growth-promoting endophytic bacteria from the roots of the medicinal plant Aloe vera. S. Afr. J. Bot. 2019, 134, 3–16. [Google Scholar] [CrossRef]
- Toral, L.; Rodríguez, M.; Béjar, V.; Sampedro, I. Antifungal activity of lipopeptides from Bacillus XT1 CECT 8661 against Botrytis cinerea. Front. Microbiol. 2018, 9, 1315. [Google Scholar] [CrossRef]
- Ullah, I.; Khan, A.R.; Park, G.-S.; Lim, J.-H.; Waqas, M.; Lee, I.-J.; Shin, J.-H. Analysis of phytohormones and phosphate solubilization in Photorhabdus spp. Food Sci. Biotechnol. 2013, 22, 25–31. [Google Scholar] [CrossRef]
- Lacava, P.T.; Azevedo, J.L. Endophytic Bacteria: A Biotechnological Potential in Agrobiology System. In Bacteria in Agrobiology: Crop Productivity; Maheshwari, D.K., Saraf, M., Aeron, A., Eds.; Springer: Berlin/Heidelberg, Germany, 2013; pp. 1–44. [Google Scholar]
- Dias, A.C.F.; Costa, F.E.C.; Andreote, F.D.; Lacava, P.T.; Teixeira, M.A.; Assumpção, L.C.; Araújo, W.L.; Azevedo, J.L.; Melo, I.S. Isolation of micropropagated strawberry endophytic bacteria and assessment of their potential for plant growth promotion. World J. Microbiol. Biotechnol. 2009, 25, 189–195. [Google Scholar] [CrossRef]
- Salisbury, F.; Ross, C. Plant Physiology, 4th ed.; Wadsworth Publishing Company: Belmont, CA, USA, 1992. [Google Scholar]
- Sheng, X.-F.; He, L.-Y.; Huang, W.-Y. The conditions of releasing potassium by a silicate-dissolving bacterial strain NBT. Agric. Sci. China 2002, 1, 662–666. [Google Scholar]
- Abbasi, M.; Sharif, S.; Kazmi, M.; Sultan, T.; Aslam, M. Isolation of plant growth promoting rhizobacteria from wheat rhizosphere and their effect on improving growth, yield and nutrient uptake of plants. Plant Biosyst. 2011, 145, 159–168. [Google Scholar] [CrossRef]
- Hassan, S.E.L.D.; Salem, S.S.; Fouda, A.; Awad, M.A.; El-Gamal, M.S.; Abdo, A.M. New approach for antimicrobial activity and bio-control of various pathogens by biosynthesized copper nanoparticles using endophytic actinomycetes. J. Radiat. Res. Appl. Sci. 2018, 11, 262–270. [Google Scholar] [CrossRef]
- Garrity, G.; Bell, J.; Lilburn, T. Phylum XIV. Proteobacteria phyl. nov. Bergey’s Man. Syst. Bacteriol. 2005, 2, 1. [Google Scholar]
- De Vos, P.; Garrity, G.M.; Jones, D.; Krieg, N.R.; Ludwig, W.; Rainey, F.A.; Schleifer, K.-H.; Whitman, W.B. (Eds.) The Firmicutes; Springer: New York, NY, USA, 2009. [Google Scholar]
- Miller, D.; Bryant, J.; Madsen, E.; Ghiorse, W. Evaluation and optimization of DNA extraction and purification procedures for soil and sediment samples. Appl. Environ. Microbiol. 1999, 65, 4715–4724. [Google Scholar] [CrossRef]
- Wiyono, S.; Sopandie, D.; Santosa, D. The Potency of Bacterial Associating Endemic Plants of The Java Coastal Area in Inducing Salt Tolerant in Agricultural Crops. In Proceedings of the IOP Conference Series: Earth and Environmental Science, Banda Aceh, Indonesia, 26–27 September 2018. [Google Scholar]
- Ahmad, F.; Ahmad, I.; KHAN, M.S. Indole acetic acid production by the indigenous isolates of Azotobacter and fluorescent Pseudomonas in the presence and absence of tryptophan. Turk. J. Biol. 2005, 29, 29–34. [Google Scholar]
- Wen, C.-M.; Tseng, C.-S.; Cheng, C.-Y.; Li, Y.-K. Purification, characterization and cloning of a chitinase from Bacillus sp. NCTU2. Biotechnol. Appl. Biochem. 2002, 35, 213–219. [Google Scholar] [CrossRef]
- Singh, P.; Kumar, V.; Agrawal, S. Evaluation of Phytase Producing Bacteria for Their Plant Growth Promoting Activities. Int. J. Microbiol. 2014, 2014, 426483. [Google Scholar] [CrossRef]
- Jasim, B.; John Jimtha, C.; Jyothis, M.; Radhakrishnan, E.K. Plant growth promoting potential of endophytic bacteria isolated from Piper nigrum. Plant Growth Regul. 2013, 71, 1–11. [Google Scholar] [CrossRef]
- Landa, B.B.; Hervás, A.; Bettiol, W.; Jiménez-Díaz, R.M. Antagonistic activity of Bacteria from the chickpea rhizosphere againstFusarium Oxysporum f. sp. Ciceris. Phytoparasitica 1997, 25, 305–318. [Google Scholar] [CrossRef]
- Zhao, S.; Zhou, N.; Zhao, Z.-Y.; Zhang, K.; Wu, G.-H.; Tian, C.-Y. Isolation of Endophytic Plant Growth-Promoting Bacteria Associated with the Halophyte Salicornia europaea and Evaluation of their Promoting Activity Under Salt Stress. Curr. Microbiol. 2016, 73, 574–581. [Google Scholar] [CrossRef] [PubMed]
- AOAC International. Official Methods of Analysis of AOAC International, 20th ed.; Association of Official Analytical Chemists: Rockville, MD, USA, 2016; p. 3172. [Google Scholar]

| Bacterial Strain Code/Accession Number | Homologue Sequences (Sequence Identity %) | NCBI Accession Numbers | NaCl Tolerance | |||
|---|---|---|---|---|---|---|
| 100 mM | 150 mM | 200 mM | 250 mM | |||
| PI-1/MT994669 | Agrobacterium fabrum (99.8%) | NR_074266 | ++ | ++ | + | − |
| PI-3/MT994670 | Acinetobacter radiresistens (99.8%) | NR_114074 | ++ | + | − | − |
| PI-5/MT994671 | Brevibacillus brevis (99%) | NR_115589 | ++ | ++ | + | − |
| PI-8/MT994672 | Bacillus cereus (99.6%) | NR_115714 | ++ | ++ | + | − |
| PI-10/MT994673 | Bacillus subtilis (99.4%) | NR_113265 | ++ | ++ | + | − |
| PI-12/MT994674 | Paenibacillus barengoltzii (99.3%) | NR_113988 | ++ | + | + | − |
| PI-15/MT994675 | Burkholderia cepacia (99.7%) | NR_113645 | ++ | + | − | − |
| Bacterial Isolates | The Diameter of Clear Zones (mm) | |||||
|---|---|---|---|---|---|---|
| Amylase | Protease | Xylanase | Cellulase | Chitinase | Catalase | |
| PI-1 | 0 b | 14.9 ± 0.1 b | 14 ± 0.1 ab | 14.7 ± 0.1 d | 13 ± 0.2 ab | + |
| PI-3 | 0 b | 13.5 ± 0.2 b | 12 ± 0.2 bc | 15.5 ± 0.03 cd | 12 ± 0.1 b | + |
| PI-5 | 10 ± 0.1 a | 14 ± 0.1 b | 11.6 ± 0.1 c | 15.9 ± 0.1 cd | 0 c | + |
| PI-8 | 12.8 ± 0.2 a | 17.5 ± 0.3 a | 16 ± 0.1 a | 19 ± 0.1 ab | 15 ± 0.2 a | + |
| PI-10 | 11 ± 0.2 a | 15.6 ± 0.3 b | 15 ± 0.2 a | 21.8 ± 0.1 a | 13.9 ± 0.1 ab | + |
| PI-12 | 10.5 ± 0.3 a | 14 ± 0.2 b | 12 ± 0.2 bc | 18 ± 0.1 b | 11.5 ± 0.1 b | + |
| PI-15 | 0 b | 0 c | 11 ± 0.2 c | 17 ± 0.1 bc | 0 c | + |
| Bacterial Isolate | Ammonia Production | P Solubilization Diameter of the Clear Zone (mm) |
|---|---|---|
| PI-1 | + | 5.6 ± 0.4 c |
| PI-3 | + | 6 ± 0.5 bc |
| PI-5 | ++ | 0 d |
| PI-8 | ++ | 9.8 ± 0.8 a |
| PI-10 | ++ | 7 ± 0.7 b |
| PI-12 | + | 0 d |
| PI-15 | + | 0 d |
| Bacterial Isolate | Percentage of Growth Inhibition (%) | ||
|---|---|---|---|
| Fusarium oxysporum | Alternaria alternata | Pythium ultimum | |
| PI-1 | 22 ± 0.3 e | 23.8 ± 0.2 e | 18.5 ± 0.2 cd |
| PI-3 | 23.8 ± 0.2 e | 22.5 ± 0.3 e | 15.9 ± 0.3 e |
| PI-5 | 45.6 ± 0.3 c | 38.8 ± 0.2 c | 17 ± 0.1 de |
| PI-8 | 48.9 ± 0.03 b | 46 ± 0.1 b | 20 ± 0.2 b |
| PI-10 | 52.6 ± 0.2 a | 50 ± 0.2 a | 24 ± 0.2 a |
| PI-12 | 24 ± 0.2 e | 31.7 ± 0.4 d | 19 ± 0.1 bc |
| PI-15 | 33 ± 0.1 d | 37.5 ± 0.3 c | 17 ± 0.1 de |
| Bacterial Treatments | Root Length (cm) | Root Biomass (mg) | |
|---|---|---|---|
| Fresh Weigh | Dry Weight | ||
| Control | 19.5 ± 1.6 c | 1529 ± 43.6 b | 305.8 ± 16.6 c |
| PI-8 | 28 ± 1 a | 1804 ± 36 a | 505 ± 26 a |
| PI-10 | 25 ± 1 b | 1766.8 ± 29.9 a | 441.7 ± 14 b |
| Bacterial Treatments | Plant Height (cm) | Growth Performance | Shoot Nutrient Content | |||||
|---|---|---|---|---|---|---|---|---|
| Fresh Weight (mg) | Dry Weight (mg) | P (%) | K (%) | N (%) | ||||
| Shoot | Root | Shoot | Root | |||||
| Control | 29 ± 0.5 d | 515 ± 3.0 d | 1512 ± 4 d | 69.7 ± 0.6 d | 354.6 ± 4.5 d | 0.18 ± 0.006 b | 2.06 ± 0.06 a | 1.4 ± 0.03 a |
| PI-8 | 38.9 ± 0.3 b | 651.7 ± 3.8 b | 1820 ± 5 b | 85.7 ± 2.5 b | 514 ± 4 b | 0.23 ± 0.006 ab | 2.3 ± 0.06 a | 1.5 ± 0.02 a |
| PI-10 | 34 ± 0.8 c | 601.7 ± 4 c | 1784 ± 4 c | 76 ± 2.6 c | 449 ± 1 c | 0.2 ± 0.006 ab | 2.2 ± 0.03 a | 1.5 ± 0.01 a |
| Consortium (PI-8 + PI-10) | 44.9 ± 0.2 a | 718 ± 3.5 a | 1918 ± 5.5 a | 96 ± 1.7 a | 596 ± 5 a | 0.34 ± 0.01 b | 2.4 ± 0.05 a | 1.6 ± 0.02 a |
Publisher’s Note: MDPI stays neutral with regard to jurisdictional claims in published maps and institutional affiliations. |
© 2021 by the authors. Licensee MDPI, Basel, Switzerland. This article is an open access article distributed under the terms and conditions of the Creative Commons Attribution (CC BY) license (http://creativecommons.org/licenses/by/4.0/).
Share and Cite
Fouda, A.; Eid, A.M.; Elsaied, A.; El-Belely, E.F.; Barghoth, M.G.; Azab, E.; Gobouri, A.A.; Hassan, S.E.-D. Plant Growth-Promoting Endophytic Bacterial Community Inhabiting the Leaves of Pulicaria incisa (Lam.) DC Inherent to Arid Regions. Plants 2021, 10, 76. https://doi.org/10.3390/plants10010076
Fouda A, Eid AM, Elsaied A, El-Belely EF, Barghoth MG, Azab E, Gobouri AA, Hassan SE-D. Plant Growth-Promoting Endophytic Bacterial Community Inhabiting the Leaves of Pulicaria incisa (Lam.) DC Inherent to Arid Regions. Plants. 2021; 10(1):76. https://doi.org/10.3390/plants10010076
Chicago/Turabian StyleFouda, Amr, Ahmed M. Eid, Albaraa Elsaied, Ehab F. El-Belely, Mohammed G. Barghoth, Ehab Azab, Adil A. Gobouri, and Saad El-Din Hassan. 2021. "Plant Growth-Promoting Endophytic Bacterial Community Inhabiting the Leaves of Pulicaria incisa (Lam.) DC Inherent to Arid Regions" Plants 10, no. 1: 76. https://doi.org/10.3390/plants10010076
APA StyleFouda, A., Eid, A. M., Elsaied, A., El-Belely, E. F., Barghoth, M. G., Azab, E., Gobouri, A. A., & Hassan, S. E.-D. (2021). Plant Growth-Promoting Endophytic Bacterial Community Inhabiting the Leaves of Pulicaria incisa (Lam.) DC Inherent to Arid Regions. Plants, 10(1), 76. https://doi.org/10.3390/plants10010076

